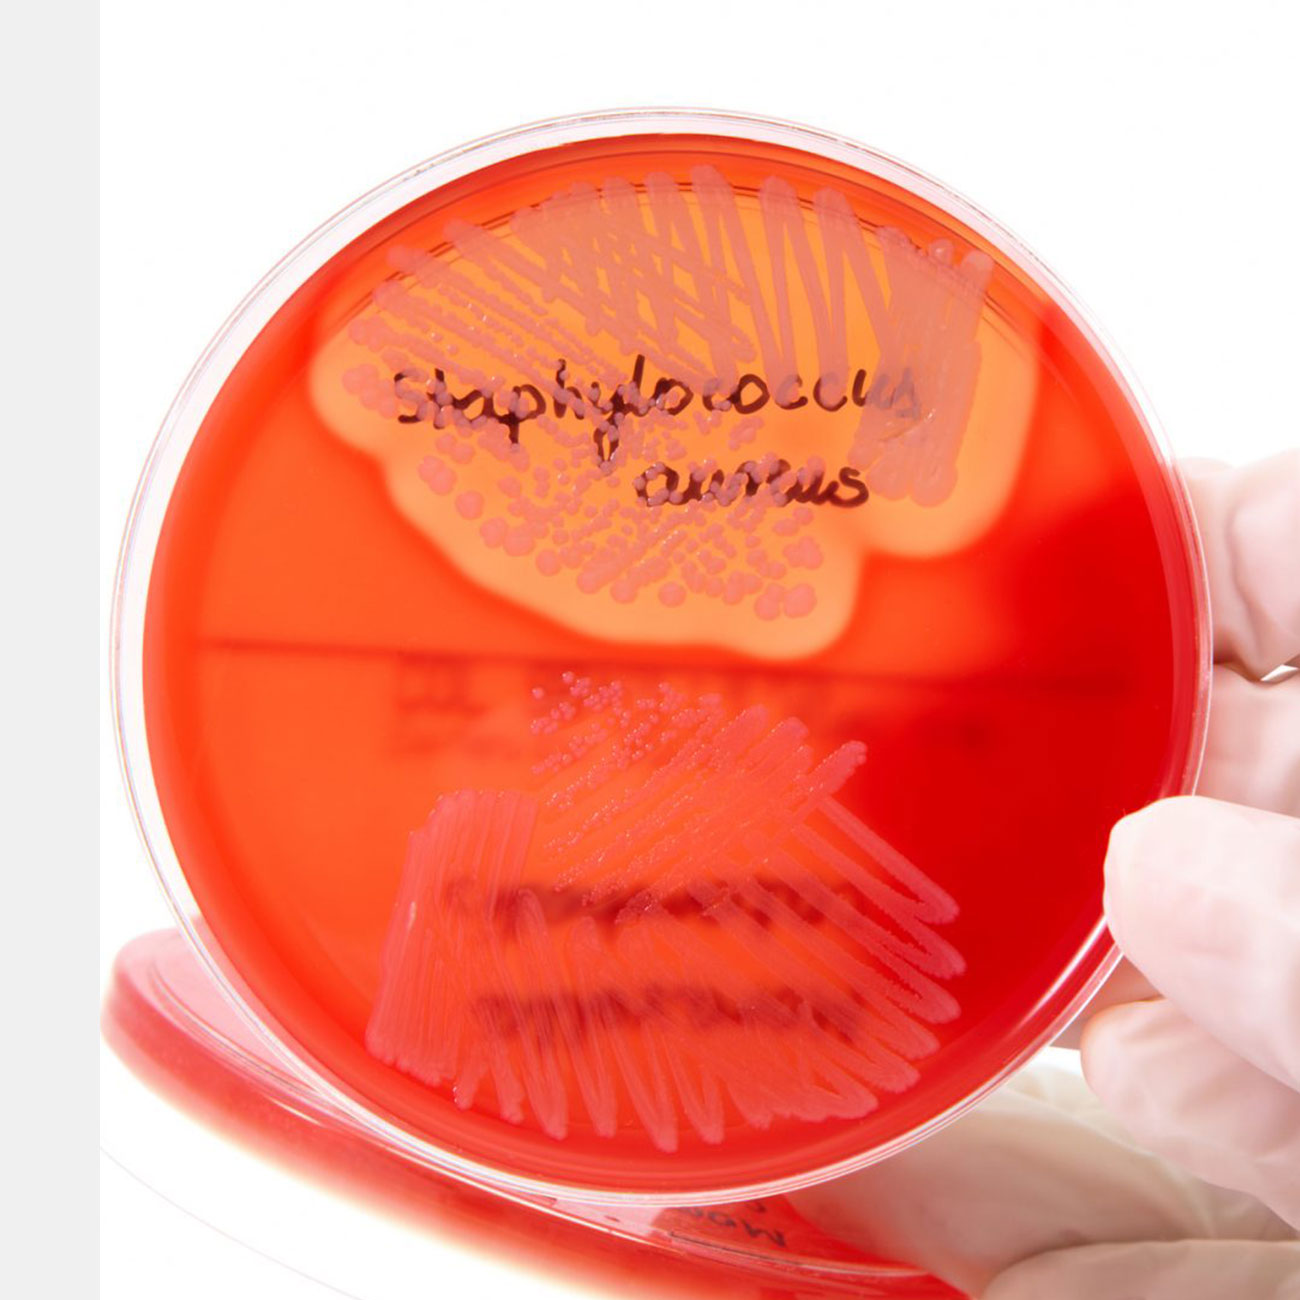

Компания из ЮАР Afrigen создала первую в мире мРНК-вакцину на основе открытых технологий Moderna. Препарат еще не прошел даже доклинические исследования. Американская компания отказалась официально делиться технологиями.
Устойчивость бактерий к антибиотикам — одна из ведущих причин смертности в мире. Об этом сообщает команда медиков в редакционной колонке в престижном научном журнале The Lancet. Авторы статьи бьют тревогу: из-за антибиотикорезистентности умирает больше людей, чем от малярии и ВИЧ. Так, в 2019 году смерть 4,95 млн человек была связана с инфекциями, резистентными к воздействию лекарств.
ВОЗ призвала мировые страны обновить имеющиеся у них вакцины против COVID-19 для эффективного противодействия варианту коронавируса «Омикрон». Препараты должны основываться на материале, генетически и антигенно близком к нынешним штаммам COVID-19, чтобы и дальше соответствовать критериям ВОЗ.
There is a new digital thermometer BCool that works without a battery.
В меняющихся климатических условиях выращивание старых сельхозкультур становится более затратным, а иногда и невозможным, а на выведение и/или акклиматизацию новых могут уйти десятилетия. Однако применение технологии редактирования генома CRISPR может помочь быстро создать экоустойчивые сельскохозяйственные растения.